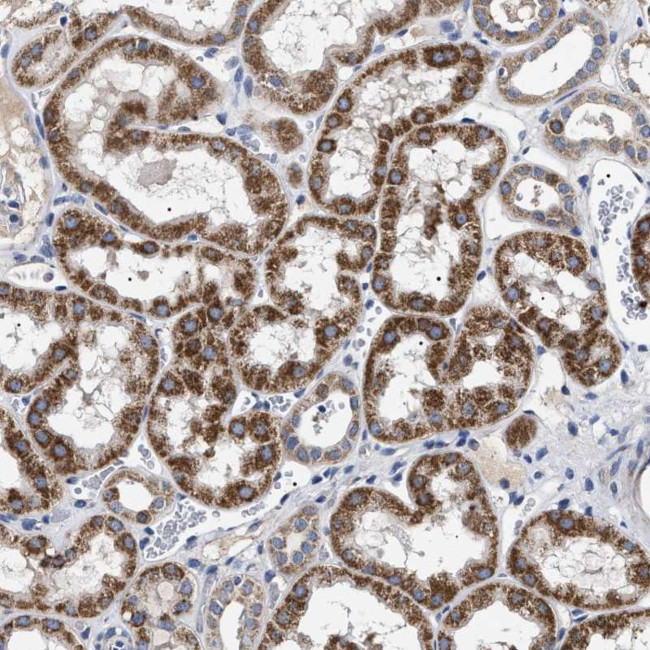
CHRDL2 Antibody in Immunohistochemistry (Paraffin) (IHC (P))

Search
Invitrogen
CHRDL2 Polyclonal Antibody
{{$productOrderCtrl.translations['antibody.pdp.commerceCard.promotion.promotions']}}
{{$productOrderCtrl.translations['antibody.pdp.commerceCard.promotion.viewpromo']}}
{{$productOrderCtrl.translations['antibody.pdp.commerceCard.promotion.promocode']}}: {{promo.promoCode}} {{promo.promoTitle}} {{promo.promoDescription}}. {{$productOrderCtrl.translations['antibody.pdp.commerceCard.promotion.learnmore']}}
产品信息
PA5-82773
种属反应
宿主/亚型
分类
类型
抗原
偶联物
形式
浓度
规格
纯化类型
保存液
内含物
保存条件
运输条件
RRID
产品详细信息
Immunogen sequence: RVLVHTSVSP SPDNLRRFAL EHEASDLVEI YLWKLVKGIF HLTQIKKVRK QDFQKEAQHF RLLAGPHEGH WNVFLAQTLE LKVTASPDKV TKT
Highest antigen sequence indentity to the following orthologs: Rat - 76%, Mouse - 77%.
靶标信息
CHRDL2 encodes a member of the chordin family of proteins. Chordin family members are secreted proteins that share a cysteine-rich pro-collagen repeat domain and associate with members of the transforming growth factor beta superfamily. In vitro assays demonstrate a direct interaction between the encoded protein and human activin A. This gene is expressed in many tissues including osteoblasts, where it is differentially expressed during differentiation. In addition, its expression is upregulated in human osteoarthritic joint cartilage, suggesting a role in adult cartilage regeneration.
仅用于科研。不用于诊断过程。未经明确授权不得转售。
篇参考文献 (0)
生物信息学
蛋白别名: BNF-1; Breast tumor novel factor 1; CHL2; Chordin-like protein 2; Chordin-related protein 2; FKSG37; unnamed protein product
基因别名: BNF1; CHL2; CHRDL2; UNQ765/PRO1557
UniProt ID: (Human) Q6WN34
Entrez Gene ID: (Human) 25884